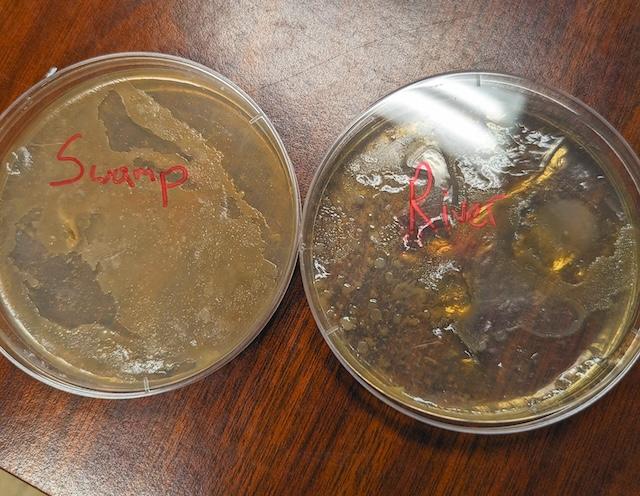

Oliver Clegg, program director for the Vestal Boys and Girls Club, gave some great insights on the benefits of the creative education of the Boys and Girls Clubs.
One of the most important advantages teachers like Oliver have is the freedom to create curriculum based on the ideas suggested by the students rather than dictated by standards.
Clegg says as a science teacher he can use that freedom to make lasting impressions and memories for the youth, “so I’m a pretty lucky guy for getting to play Bill Nye for the Tennessee Valley.”
Recently, the students wanted to research the Vestal area water and swamp areas. Through community and grant funding, the teachers built an entire six-week course on marine biology, simply because the kids requested it and have shown interest in the subject. Oliver said fostering the student curiosity is the teachers job and they love it.
In this particular experiment, Oliver took notice of an insect-covered swamp and small clean stream on a trail near the building. After wondering what might be living in them, he brought it up to one student and after some conversation, he asked if they wanted to find out.
They gathered a group of curious kids, attached a beaker to a grabber, took a few liquid sample containers and set out for discovery.
The group talked about the dangers of stagnant water, common bacteria, insect eggs and parasites, while picking spots to choose their samples.
After taking the samples back, the group set up microscopes, prepared slides and used methylene blue stain to identify the microscopic life within the samples.
- Swamp adventure
- Water testing
- Samples for testing
The entire process covered days, and any educator would recognize the many skills implemented throughout this process that are covered in the tested standards. Using this project-based learning method ingrains those skills in a way that students love learning instead of dreading it.
Info: Boys & Girls Clubs of the Tennessee Valley.
All of us have a story and I want to tell yours! Send them to susan@knoxtntoday.com